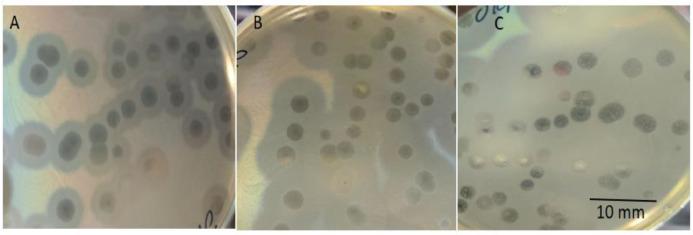
https://cdn.ncbi.nlm.nih.gov/pmc/blobs/36dc/10194101/6b1614ecb309/gr1.jpg

一种 K-17 血清型特异性肺炎克雷伯菌噬菌体 JKP2,具有减少生物膜的潜力。
A K-17 serotype specific Klebsiella phage JKP2 with biofilm reduction potential.
机构信息
Institute of Microbiology and Molecular Genetics, University of the Punjab, Lahore, Pakistan; Department of Pathology, King Edward Medical University, Lahore, Pakistan.
Institute of Microbiology and Molecular Genetics, University of the Punjab, Lahore, Pakistan; Department of Microbiology, Hazara University, Mansehra, Pakistan.
出版信息
Virus Res. 2023 May;329:199107. doi: 10.1016/j.virusres.2023.199107. Epub 2023 Apr 2.
Klebsiella pneumoniae is an opportunistic pathogen responsible for nearly one-third of all Gram-negative infections. Increasing antibiotic resistance has pushed scientists to look for alternative therapeutics. Bacteriophages have emerged as one of the promising alternatives. In the current study, the Klebsiella phage JKP2 was isolated from a sewage sample and characterized against the K-17 serotype of K. pneumoniae. It produced bulls-eye-shaped clear plaques and has a latent period of 45 min with a burst size of 70 pfu/cell. It remained stable at tested pH (5 to 10) and temperatures (37 to 60 °C). Its optimum temperature for long-term storage is 4 °C and -80 °C. The JKP2 showed its infectivity against the K. pneumoniae K-17 serotype only. It controlled planktonic cells of K. pneumoniae 12 h post-incubation. At MOI-1, it efficiently eliminated 98% of 24 and 96% of 48-hour-old biofilm and 86% and 82% of mature biofilm of day 3 and 4, respectively. The JKP2 has an icosahedral capsid of 54 ± 0.5 nm with a short, non-contractile tail, measuring 12 ± 0.2 nm. It possesses a double-stranded DNA genome of 43.2 kbp with 54.1% GC content and encodes 54 proteins, including 29 with known functions and 25 with unknown functions. JKP2 was classified as Drulisvirus within the Autographiviridae family. It uses a T7-like direct terminal repeat strategy for genome packaging. JKP2 can be applied safely for therapeutic purposes as it does not encode an integrase or repressor genes, antibiotic resistance genes, bacterial virulence factors, and mycotoxins.
肺炎克雷伯菌是一种机会致病菌,可导致近三分之一的革兰氏阴性菌感染。不断增加的抗生素耐药性促使科学家寻找替代疗法。噬菌体已成为一种很有前途的替代品。在本研究中,从污水样本中分离出一株肺炎克雷伯菌噬菌体 JKP2,并针对肺炎克雷伯菌 K-17 血清型进行了鉴定。它产生牛眼状清晰噬菌斑,潜伏期为 45 分钟,爆发量为 70 个空斑形成单位/细胞。它在测试的 pH 值(5 至 10)和温度(37 至 60°C)下均保持稳定。其长期储存的最佳温度为 4°C 和-80°C。JKP2 仅对肺炎克雷伯菌 K-17 血清型表现出感染性。孵育 12 小时后,它可控制肺炎克雷伯菌浮游细胞。在 MOI-1 时,它能有效清除 24 小时和 48 小时老化生物膜的 98%和 96%,以及第 3 天和第 4 天成熟生物膜的 86%和 82%。JKP2 具有一个 54±0.5nm 的二十面体衣壳,带有一个短的、不可收缩的尾巴,长 12±0.2nm。它具有一个 43.2kbp 的双链 DNA 基因组,GC 含量为 54.1%,编码 54 种蛋白质,其中 29 种具有已知功能,25 种具有未知功能。JKP2 被归类为 Autographiviridae 科的 Drulisvirus。它使用类似于 T7 的直接末端重复策略进行基因组包装。由于 JKP2 不编码整合酶或抑制基因、抗生素耐药基因、细菌毒力因子和霉菌毒素,因此可以安全地应用于治疗目的。